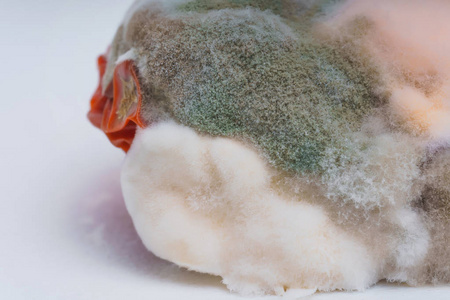
毛霉摄影图

毛霉

毛霉
图片尺寸900x670
毛霉目
图片尺寸2667x2000
食物发霉长毛了还能不能吃看上去就害怕不要轻易尝试
图片尺寸700x907
毛霉科mucoraceae
图片尺寸800x533
毛霉菌又叫黑霉,长毛霉,外观呈黑色/棕色的绒毛状,是一类广泛存在于
图片尺寸640x480
毛霉生长旺盛
图片尺寸1270x1246
毛霉菌是一大类广泛存在于自然界的真菌,虽然我们所
图片尺寸438x427
毛豆腐曲粉发酵盘霉豆腐乳曲毛豆腐菌长毛菌种毛霉菌种白毛毛霉菌 100
图片尺寸803x646
毛霉目
图片尺寸2000x2667
毛霉摄影图
图片尺寸450x300
直撒腐乳曲毛霉菌种毛豆腐霉豆腐霉千张霉豆渣臭豆腐菌400g白毛霉豆渣
图片尺寸990x1320
毛霉
图片尺寸1488x1984
落叶上的毛霉mucor.
图片尺寸1080x715
【你好!大自然】第141期:山药君的发型--某毛霉
图片尺寸1080x810
【你好!大自然】第141期:山药君的发型--某毛霉
图片尺寸1080x810
毛霉目
图片尺寸1080x2287
环境工程微生物技术
图片尺寸632x268
毛霉目
图片尺寸2000x2667
毛霉
图片尺寸1009x1009
毛霉的生长需要哪些条件?
图片尺寸600x380